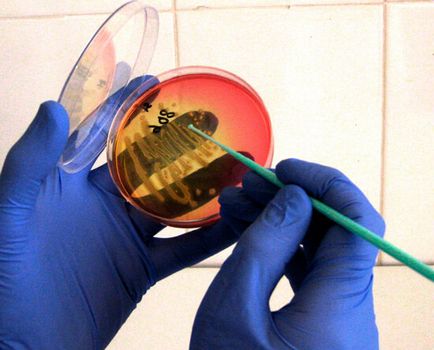

Hogyan és mit kell kezelni egy orrfolyás az újszülött áttekintést hatékony eszközök és módszerek
Mielőtt kezelni orrfolyás egy újszülött, meg kell érteni, hogy miért nem merült fel, és hogy szükséges-e kezelni egyáltalán.
A legtöbb esetben, orrfolyás gyermekeknél az első hónapban az élet nem következménye a betegség, és nem igényel kezelést. Részletes oka a megfázás ebben a korban, áttekintettük a cikket orrfolyás csecsemők egyáltalán. És most azt látjuk, hogy mit kell csinálni a szülők minden helyzetben, és hogyan kell kezelni egy orrfolyás egy újszülött, ha valóban szükség van.

Amikor kezelésére orrfolyás nem szükséges
Újszülött nem köteles gyógyszeres kezelést alkalmazni:
- Fiziológiai nátha kinyúló születés és általában tart 1-2 hónap előtt adaptációs nyálkahártyát normális légzés levegőt paraméterek;
- A reakció különböző irritáló a levegőben;
- A szárítási az orrnyálkahártya miatt túl meleg és száraz levegő a szobában.
Mindezek légzészavar normalizálódott egyszerű szervezeti eljárások.
Fiziológiás rhinitis a gyermek és a reakció, hogy a száraz levegő a szobában a szülők kell tennie mindent annak érdekében, az időben történő eltávolítása felesleges váladék az orrból a baba, és megakadályozzák, hogy a kiszáradástól. Még egy kis feleslegben nyálka a újszülött elzáródásához vezethet az orrjáratok és az orrdugulás, mint a rések a felső légutak ebben a korban nagyon kicsi. Ezért, ha az újszülött jelentősen nyilvánul fiziológiai hideg, a szülők, hogy:
- Párásítására levegő a szobában, hogy elérjék 60-75% nedvességet;
- Rendszeresen - 1 vagy 2-szer egy nap -, hogy távolítsa nyavalyog az orra meg elszívóval;
- Hogy a baba inni vizet vagy speciális gyermek teák. Az anyatej nem terjed ki a gyermek testének szükséglete felesleges folyadékot, és ezért csak az egyik szoptatás nem lehet elég ahhoz, hogy a nyálka az orr, a gyerek állt ki a szokásos mennyiségben.

Saline legalkalmasabb hidratálódni kiszáradt orrnyálkahártya
A nyilvánvaló jelei kiszárítja a orrnyálkahártya újszülött becsepegtetendő mindegyik orrlyukba 1-2 csepp sóoldatot vagy otthoni főtt sós vízben (egy liter vízben teáskanál só). Akkor cserélje ki őket azokkal az eszközökkel alapján a tengervíz.
Csecsemők nem lehet mosni, vagy az orr pshikat neki mit spray. Sok hidratáló alapján tengervíz most végre az orrspray vagy douches. Használatuk alatti gyermekeknél egy év veszélyes! Újszülöttek csak becsepegtetendő orrcsepp.
Cseppentve az orr újszülött olaj lágyító nyálkahártya csak akkor, ha a száraz kéreg, csak a hiányában a folyadék (akár vastag) a fúvóka, és csak olyan esetekben, amikor ez lehetetlen használni sóoldat. Ez általában úgy történik, mielőtt az éjszakai alvást. Alkalmazása előtt az olajcseppek kell orvoshoz fordulni.
A lényeg az, hogy a szülők meg kell emlékezni: megszabadulni a nátha fiziológiai újszülött nem tud. Minden, amit tehetnek - várja, hogy vége legyen, és a gyermek kényelmének állapotban.
Ha nátha újszülött válasz a szennyező a levegőben, azt kell először pontosan meghatározni az ilyen irritáló anyagok, és azok megszüntetésére. Ez nem mindig könnyű megtenni, de ez a helyzet, amikor a szülők segíthetnek az újszülött egy hideg több, mint egy orvos.

Néha háziállat együttélés irritációt okozhat az orrnyálkahártya, a gyermek
A legtöbb esetben a gyerekek reagálnak a jelenléte orrfolyás a levegőben ezen anyagok:
- Klór csapvíz vagy tisztítószerek;
- A cigarettafüst;
- por;
- Pet haj és a madártoll.
Valószínű, hogy ha megszünteti ezeket a bosszantó ügynökök, a gyermek elmúlik nátha. Ehhez:
- Cserélje ki az összes ilyen tisztítószerek, amely nem tartalmaz klórt;
- Víz fürdés a gyermek forralás vagy megvédeni, legalább egy nap;
- Ne engedje, hogy bárki dohányozzon olyan lakásban vagy az erkélyen, vagy a lépcsőházban, és hazatérve a lakásban - a gyermek légzés;
- Vegyük ki a helyiségben, ahol a legtöbb időt a baba, mind az extra dolgokat, bútorok, szőnyegek, festmények beleértve. Mindegyikük - por elem, amely képes reagálni és az újszülött;
- Legalább egyszer két nap alatt nedves tisztítás a szobában;
- Abban az időben, távolítsa el a házból a háziállatok és madarak.

Néha az orvos lépett be a terembe csak kiszámítja, mely anyag okozza orrfolyás a gyermek
Ha éppen akkor az orr az újszülött határozza, meg kell hívni a gyermekorvos vagy védőnő. Mint a szakember gyakran szembesülnek hasonló helyzetekben a tapasztalat lehet mondani neki, hogy a levegő a szobában lehet az oka a nátha a gyermekek körében. És ahogy egy ember, aki nincs hozzászokva, hogy az adott körülmények között az a lakás, akkor könnyen észre a különleges illatok, a hangulat és a klíma az első percekben a látogatás.
De mi van, ha a orrfolyás az újszülött kíséri magas testhőmérséklet, azaz egyértelmű fertőző betegség egy gyulladásos folyamat?
Fertőző betegségek újszülöttek általában nem fordul elő. Hat hónap után az élet úgy - normális, de az élet első hónapjaiban a gyermek által védett anyai immunitás nem ragaszkodnak a vírusok vagy baktériumok. Megérteni, hogy miért a gyermek volt ilyen kivétel csak egy orvos. Ha hallgat a baba, ő határozza meg, hogy csak az orr-rész fertőzés alakul ki, vagy úgy költözött be a tüdőbe, a vírus okozta betegség vagy baktériumok. És ami a legfontosabb: tudja megérteni, mi orvosolni megfázás újszülöttek is igaz, hogy a gyermek, amikor általános fiziológiai állapotának, annak immunitás és egyéb jellemzőit.

Láz és fertőzés az újszülött - egy veszélyes helyzet
De az önálló nátha kezelésére csecsemők, köztük népi jogorvoslati nélkül a tapasztalat és a megértés az elvek a fertőzés és a gyógyszer hatását vezethet nagyon súlyos következményei lehetnek. Elégeti az orrnyálkahártyán, súlyos allergia és gyulladás a tüdő - csak néhány közülük.
Tudom, csak hogyan kell kezelni egy orrfolyás csecsemőknél, a szülők kell csak felismerni szólva rossz recept (sajnos néha vannak ilyen), és az időben, hogy egy másik szakember.
Vírusos nátha és annak szabályai kezelés
A fő meghatározó tünetek vírusos nátha, ami a megfelelő orrfolyás - láz a gyermek, levertség, étvágytalanság, bőséges folyadék tiszta és takony. A klinikai vizsgálatokban, orrváladék kenet benne nagyszámú jól meghatározott limfocita - sejtek hatékonyan harci vírusrészecskéket.

Limfociták - vérsejtek, hogy harcolni idegen részecskék (vírusok, baktériumok és más hasonló)
Szigorúan véve, hogy gyógyítani a vírusos nátha nem lehet egy újszülött. Az alapvető viráiis részecskék mennyisége a betegség a sejtekben az orrnyálkahártya, ahol működhet nem gyógyszer. Elpusztítani a vírust részecskék csak összetevői az immunrendszer a baba testét.
Legyen felkészülve arra, hogy ha az újszülött SARS, kevesebb, mint egy hét, a betegség nem kerül sor. Tisztán elvileg a testnek szüksége van legalább 5-6 nappal az antitestek termelését a vírus, és még néhány napon belül teljes megszüntetése (megsemmisítése) a meglévő test virális részecskék. 2-3 nap gyógyítani vírusos nátha az újszülött nem fog működni.
Emiatt az összes bevételt a közönséges nátha vírusa az újszülött célja az immunrendszert támogató, és a feltételek megteremtése, amelyben a szervezet maga a lehető leggyorsabban, hogy megbirkózzanak a vírus. Ehhez meg kell tennie mind ugyanaz történt a gyermek fiziológiai hideg. Rendkívül fontos, hogy a vírusfertőzés során takony volt folyadék és folyamatosan folyt a gyermek orrát.
Továbbá, ha nyilvánvalóvá válik, hogy a gyermek teste nem tud megbirkózni a fertőzés, akkor lehet rendelni:
- Immunomodulátor gyógyszereknek alapuló interferon - gyertyák Viferon, Kipferon, orrcseppek Grippferon, Derinat oldatok, IRS-1. Nem minden orvos egyetért az ésszerűség és megvalósíthatóságát használ ilyen eszközöket, mint bizonyítottan hatékony ezen alapok nem, és a munka elsősorban a placebo módban. De azt is jelentős mellékhatásai, ezért csecsemőknek beadhatók nagyon kis mennyiségben, és csak kivételes esetekben a döntés az orvos.
- Antiszeptikumok, csökkentve a vírusrészecskék száma a nazális nyálkahártya, és megakadályozzák a fertőzés terjedését. Ma ilyen eszköz Oktenisept, Okomistin Miramistin és megsemmisítésének sok vírus, a részecskék, amelyek jelentős méretű. Azonban, ha Ukrajna azonos Okomistin használatra jóváhagyott gyermekgyógyászati betegek Magyarországon 18 éves használata tilos. Sőt, komoly vizsgálatok megerősítették hatásosságát és biztonságosságát csecsemők végeztünk. Más antiszeptikumok helyzet hasonló, azonban az ezek hasznosságát kezelésére szolgáló szerek, nátha nem egyértelmű.

Oktenisept - fertőtlenítő gyógyszer helyi használatra
Nem lehet antibiotikumokkal kezelik vírusos nátha csecsemőknél. Ez egy teljes szabályok megsértésével az antibiotikumok használata, jelezve a felelőtlen megközelítés az, aki kezeli a munkát. Az antibiotikumok haszontalan a vírusok ellen. Ha az orvos diagnosztizálja az ARI, és így ír egy antibiotikum, akkor jobb, hogy konzultáljon egy párhuzamosan egy másik orvost.
Kezelésére orrfolyás egy újszülött gyakran szükséges a használata tüneti kezelés.
A növekedést a testhőmérséklet 38 ° C-on és magasabb kell alkalmazni lázcsillapító gyógyszerek, mint a paracetamol vagy Nurofen.
Teljes hiánya orrdugulás és orrlégzés gyermek kezelőorvosa érszűkítő esik. Újszülött a megfázás lophatok Otrivin Baba, Baby Nazol, Nazivin Sensitive. Azonban annál kevésbé csöpög az orr, a gyorsabb orrfolyás át, mert ha a kérelem olyan cseppeket álljon - ez jobb tartózkodni. Minden ilyen orvosság megfázás csak egy újszülött csökkentése érdekében a hatalom nyomasztó tüneteket.

Részletek orrcsepp újszülöttek és a csecsemők, beszélgettünk egy külön cikkben.
Hogyan kell kezelni a orrfolyás bakteriális újszülött
De bakteriális nátha újszülött elég lehet kezelni. Azonban a megvalósíthatóságát ez a kezelés nem mindig egyértelmű.

Streptococcus, ami rhinitis
Az a tény, hogy a standard alkalmazási arány a hatékony antibakteriális szerek (ideértve az antibiotikumokat) általában úgy van kialakítva, 4-5 napig. Ugyanakkor, a legtöbb esetben a bakteriális rhinitis csecsemők kialakult szenvedés után vírusfertőzés, tart 2-3 napig, ezt követően a kereset az immunrendszer patogén mikroflóra orrgarat elnyomott és a gyermek visszanyeri. Tehát lehet, hogy egy olyan helyzetben, ahol a orrfolyás és a fertőzés már kimondta, és a baba meg kell inni egy pár napig antibiotikummal kialakulásának megelőzése rezisztens baktériumtörzsek. Ezért ...
Bakteriális orrfolyás újszülött csak akkor van értelme, ha 2-3 nap után, maga a betegség nem telt el, és a szervezet nem képes megbirkózni a fertőzéssel. Kivételek ez alól a szabály - a nehéz betegség, fejlesztése párhuzamosan a hideg, immunhiányos betegségek a gyermekeknél, beleértve a mesterséges immunszuppresszió, amikor a nátha kezelésére kell kezdeni az első jele.
Garantált, hogy gyógyítani bakteriális orrfolyás újszülött is, miután tanulmányok a készítmény bakteriális iszap és azonosítani a kórokozót. Ez lehetővé teszi, hogy hozzá a hatékony antibiotikumok és más antibiotikumokra is. Csak néha az orvos antibiotikumot írnak nélkül baktériumfertőzés teszt nagyon széles hatásspektrumú, amelyre a valószínűség magas, hogy fog működni.
Baktérium tenyészetének egy Petri-csészébe. A laboratóriumi törzs mikroorganizmusok és meghatározzuk azok érzékenységét az antibiotikumokkal szemben.
Újszülöttek lehet használni alapuló készítmények ilyen antibiotikumok:
Mindezek antibiotikumok sajátosságait felszívódását a szervezetben, és egy másik időszakban. Az orvos tudja kezelni orrfolyás egy újszülött velük csak ügyelve arra, hogy az antibiotikumok nem bizonyulnak sokkal veszélyesebb, mint a betegség.

Amoxicillin - antibiotikum főleg parenterális kórházban
Akkor nem csökken antibiotikumok az orrát. Mindegyikük kell nevezni, vagy parenterális, vagy injekció formájában. Szintén tilos a profilaktikus antibiotikumok alkalmazására.
Továbbá, orvosa temetve az orr fertőtlenítő típusa és Miramistin oktenisept fent tárgyalt. Cure orrfolyás újszülött, akinek a segítségével ezeket a forrásokat nem lehet, de növeli az intézkedés az antibiotikumok, amennyit csak tudnak. Tehát szükség van vizsgálni a ellenjavallatok azok kölcsönhatása más gyógyszerekkel, és mellékhatásokat.
Ezen kívül, a szülők kell, hogy tegyen intézkedéseket annak érdekében, hogy a kiszáradás elkerülése érdekében a nyálka az orr, a gyermek.
Mivel lehetetlen kezelni orrfolyás egy újszülött?
Nem engedhető meg, hogy használja a csecsemők különböző növényi gyümölcslevek csepegtetve az orrát. Még a viszonylag biztonságos Kalanchoe gyümölcslé vezethet súlyos irritációt, sőt hörgőgörcs gyermekek első hónapjaiban az élet.
Népi jogorvoslati újszülött csak sós víz csöpög az orrát. Bár általában ez a népi eszközökkel nem - ez egy normális sóoldat elő a lakásban.

Saline - oldatot egy bizonyos koncentrációjú nátrium-klorid vízben
Ráadásul egy ilyen kisgyerek, bármilyen eszközzel lehet kifogni a torokban és a légutakban. Minden népi jogorvoslati lehetőségek nem hatékonyak kis mennyiségben, és öntsük őket az orrod alá, újra és újra. Következésképpen, ha a hideg újszülött ilyen kezelés lehet nagyon veszélyes betegség.
Szintén lehetetlen kezelni egy orrfolyás az újszülött:
- Homeopátiás szerek. Nem, nincs hatása, de ugyanakkor nem igényli a hatékony gyógyszerek kezelésére orrfolyás könnyen lehet bonyolult, és mozgassa a súlyosabb formája.
- Olaj csepp, amikor a gyermek kitűnjön az orr folyékony takony. Egyeztetés nélkül egy orvos ilyen eszköz jobb, ha nem kell alkalmazni.
- Felmelegedés láb és a mustár vakolatok. Semmilyen hatást ezek az eljárások valójában nem lesz orrfolyás.
- Leejtése az orrba anyatej és a méz. Ezek az alapok csak hozzájárulnak a bakteriális fertőzés, de nem terápiás hatása nem.
De ami a legfontosabb - a kezelés a nátha az újszülött nem lehet végrehajtani anélkül, hogy orvoshoz forduljon. Ez otthon szülő amatőr gyakran vezet komolyabb következményeket a gyermek, mint a tényleges betegség. Ezért hívja fel orvosát, és hagyd, hogy a vizsgálat a gyermek minden nehéz helyzetekben.